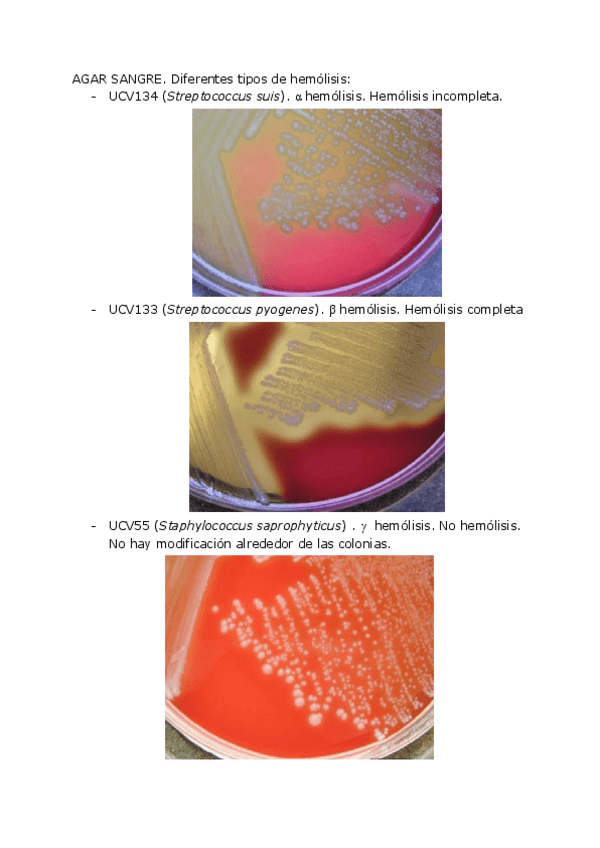

Microbiología y toxicología alimentaria
He publicado nuevos apuntes de 4º Microbiología y toxicología alimentaria: Practicas-Imp..pdf
apuntes
-
CUADERNO PRÁCTICAS
He publicado nuevos apuntes de 4º Microbiología y toxicología alimentaria: CUADERNO PRÁCTICAS
He publicado nuevos examenes de 4º Microbiología y toxicología alimentaria: examenvf.pdf
He publicado nuevos practicas de 4º Microbiología y toxicología alimentaria: Practicas-de-laboratorio.pdf
He publicado nuevos practicas de 4º Microbiología y toxicología alimentaria: PRACTICAS-MICRO.pdf
He publicado nuevos examenes de 4º Microbiología y toxicología alimentaria: EXAMEN-MICRO.pdf
He publicado nuevos apuntes de 4º Microbiología y toxicología alimentaria: T2-MICROSCOPIA-Y-TINCIONES.pdf
apuntes
-
EXAMENES MICRO
He publicado nuevos apuntes de 4º Microbiología y toxicología alimentaria: EXAMENES MICRO
apuntes
-
temario
He publicado nuevos apuntes de 4º Microbiología y toxicología alimentaria: temario
He publicado nuevos apuntes de 4º Microbiología y toxicología alimentaria: bacterias-importantes.pdf
He publicado nuevos apuntes de 4º Microbiología y toxicología alimentaria: Preguntas-y-respuestas-relacionadas-con-los-temas-de-las-exposiciones-en-grupo-20-21.pdf
He publicado nuevos apuntes de 4º Microbiología y toxicología alimentaria: Cuaderno-Practicas.pdf
He publicado nuevos apuntes de 4º Microbiología y toxicología alimentaria: Memoria-practica-7-micro.pdf
apuntes
-
Microbiología
He publicado nuevos apuntes de 4º Microbiología y toxicología alimentaria: Microbiología
apuntes
-
temario 2
He publicado nuevos apuntes de 4º Microbiología y toxicología alimentaria: temario 2
apuntes
-
temario
He publicado nuevos apuntes de 4º Microbiología y toxicología alimentaria: temario

¡Estás al día!
Has visto todos los archivos